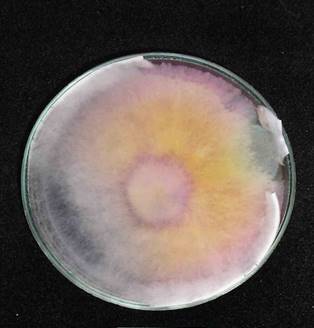
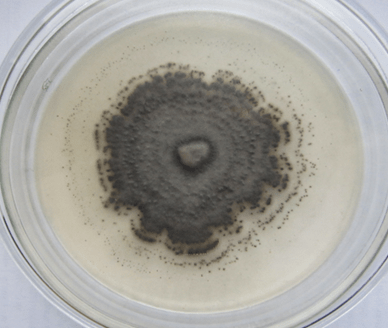
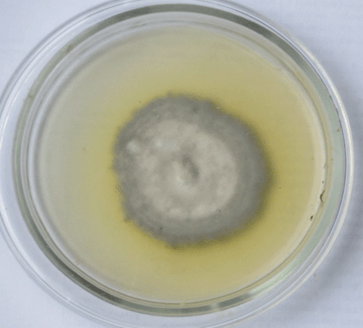
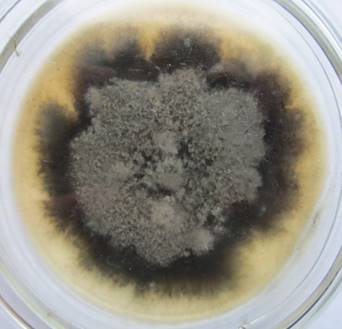

История становления станции
История началась с образования Ганусовской полеводческой опытной станции, получившей
свое название от деревни Ганусовщина (ныне Несвижского района Минской области). До 1939 года здесь
проводилась опытническая работа по сортоиспытанию и изучению отдельных приемов агротехники зерновых культур, клевера, люцерны, кормовой свеклы на минеральных почвах, улучшению естественных и
созданию сеяных лугов на торфяно-болотных почвах.
После воссоединения Западной Белоруссии станцию перевели в ведение Народного Комиссариата земледелия Белорусской ССР.В этот период сотрудники начинают вести работу по селекции озимой и яровой пшеницы, семеноводству перспективных сортов зерновых культур, продолжая исследования по улучшению лугов и пастбищ на осушенных торфяниках. Из-за оккупации Белоруссии немецко-фашистскими захватчиками в 1941 году работа ученых была прервана, и возобновить ее стало возможным только после освобождения республики в 1944 году.
Тогда перед коллективом станции были поставлены новые задачи по разработке системы агротехнических мероприятий, которые могли бы обеспечить быстрейшее восстановление и дальнейшее развитие полеводства. Так как в западных областях Беларуси большой удельный вес в посевах имел картофель, в исследованиях ученых главенствовала тематика, связанная с селекцией, семеноводством и агротехникой этой культуры. Поэтому в 1945 году принимается решение о преобразовании Ганусовской станции в опытную станцию по картофелю.
Однако в последующие годы направления исследований стали постепенно расширяться, и в 1947 году она становится Ганусовской сельскохозяйственной опытной станцией. В научную тематику включают разработку системы удобрений в севообороте, агротехники фасоли, гречихи, льна, махорки, кукурузы, многолетних трав. В это же время закладывают и первые полевые опыты с сахарной свеклой, продолжая одновременно селекционно-агротехнические исследования по картофелю, которые станут с 1965 года приоритетом Беняконской опытной станции, расположенной в Гродненской области.
В связи со строительством в республике сахарных заводов, первым из которых стал Скидельский, вступивший в строй в 1951 году, и развитием фабричного свеклосеяния, с 1956 года начали расширяться исследования по сахарной свекле, и в апреле 1959 года в результате преобразований появляется Ганусовская опытно-селекционная станция по сахарной свекле. С этого времени она становится головной научно-исследовательской организацией республики Беларусь по
селекции этой культуры и технологии ее возделывания.
В 1986 году ее переименовывают в Белорусскую зональную опытную станцию по сахарной свекле, в 2000 году – в Республиканское унитарное предприятие «Белорусская опытная станция по сахарной свекле».
В 2002 году, получив статус Республиканского унитарного предприятия «Опытная станция по сахарной свекле», она входит в состав научных учреждений и предприятий Национальной академии наук Беларуси.
За время существования станции местность, на которой она расположена, входила в состав Польши, БССР, Республики Беларусь. Несколько раз менялось название станции. Неизменным оставалось одно – ее деятельность, направленная на повышение эффективности земледельческого труда. Публикации, посвященные истории «Опытная научная станция по сахарной свекле», можно прочитать в прежних выпусках журнала «Сахарная свекла» №12/1998 и № 5/2003. ЗНАМЕНАТЕЛЬНЫЕ СОБЫТИЯ
Сахарная свекла №5/2008 3 станция, наряду с четырьмя другими научно-исследовательскими институтами, включается в состав Научно-практического центра Национальной академии наук Беларуси по земледелию.
За столь долгий путь селекционерами станции был выведен ряд сортов и гибридов сахарной свеклы, районированных не только в Республике Беларусь, но и в Российской Федерации. В государственном испытании находятся новые гибриды. В настоящее время в республике районированы сорт и гибрид сахарной свеклы собственной селекции. Налажено их семеноводство, но, к сожалению, они занимают в производственных посевах незначительный удельный вес, что связано с достаточно широким использованием гибридов иностранной селекции.
Поэтому с 2007 года на РУП «Опытная научная станция по сахарной свекле» в рамках Программы развития научно-практических центров ведутся проектные работы по созданию селекционно-семеноводческого комплекса. Ввод в эксплуатацию селекционно-семеноводческого комплекса в сочетании с применением летне-осенних посевов свежеубранными семенами позволит в течение одного года выращивать 1–2 генерации перспективных селекционных материалов сахарной свеклы, в то время как в полевых условиях на получение одной генерации уходит два года. Таким образом, селекционный процесс в целом ускорится в 2–3 раза. Будут созданы микробиологическая лаборатория, лаборатория по определению технологических качеств семян, лаборатория микроклонального размножения культуры in vitro.
На станции имеется автоматическая линия по определению технологических качеств корнеплодов «Венема», оборудование по дражированию семян сахарной свеклы фирмы Джерменс. Разработана и внедряется технология возделывания и уборки сахарной свеклы, позволяющая обеспечить выход сахара на заводе не менее 7,5 т/га при затратах труда до 0,15 человеко-часа на 1 центнер корнеплодов. Станция работает над дальнейшим совершенствованием технологии с целью снижения затрат и вредного воздействия на природную среду. Созданы новые формы удобрений для сахарной свеклы: комплексные удобрения для основного и припосевного внесения. Совместно с Клецким механическим заводом разработана конструкция сеялки для внесения стартовой дозы комплексных удобрений одновременно с посевом.
На станции большое внимание уделяется работам по коррекции минерального питания сахарной свеклы в ходе вегетации. Приобретена лаборатория функциональной диагностики «Аквадонис» Буйского химического завода, которая позволяет проводить листовую диагностику по химической активности хлоропластов, устанавливать потребность в макро- и микроэлементах задолго до появления внешних признаком голодания. Разработаны рецептуры составов для внекорневой подкормки растений. Получен патент Республики Беларусь на составы удобрительные «Свекла» для внекорневой подкормки, которые изготавливаются на станции и используются в производстве на площади 20–25 тыс. гектаров. «Опытная научная станция по сахарной свекле» тесно сотрудничает с научными учреждениями республики, стран СНГ и зарубежных государств.
Много лет партнерами станции остаются: Всероссийский институт сахарной свеклы и сахара имени А.Л. Мазлумова, Северо Кавказский научно исследовательский институт сахарной свеклы и сахара, Институт сахарной свеклы Украинской ААН, Киргизская МИС, свекло-семеноводческие фирмы «Даниско Сид» (Дания) и КВС (Германия), химические концерны и фирмы БАСФ, «Байер»(Германия), «Сингента» (Швейцария), «Август» (Россия) и др. Основная задача в области селекции сахарной свеклы на ближайшие годы – создание новых высокопродуктивных гетерозисных гибридов на основе ЦМС, в области технологии возделывания – повышение продуктивности, снижение затрат труда и негативного воздействия на окружающую среду путем оптимизации обработок, применения новых средств механизации, видов удобрений и средств защиты растений.
Значение научных разработок станции, их востребованность производством возрастают в связи с принятием правительственных программ и решений об увеличении объемов производства сахара из свеклы. Согласно «Государственной программе возрождения и развития села на 2005–2010 годы», объем производства свеклы в 2008 году должен составить 3710 тыс. тонн, в 2009 году – 3760 тыс. тонн, в 2010 году – 3810 тыс. тонн, из которых должно быть выработано по годам соответственно 400, 440 и 450 тыс. тонн свекловичного сахара. Наряду с этим в перспективе запланировано стабилизировать размер посевных площадей на уровне 80–85 тыс. га.
Следует отметить, что задачи, поставленные перед отраслью свекловодства в республике Беларусь, успешно выполняются со значительным опережением. Коллектив «Опытной научной станции по сахарной свекле» активно пропагандирует достижения и итоги своих научных разработок. Положительные результаты полевых опытов и лабораторных исследований проверяются в производственных условиях на опытно-демонстрационных полях, которые ежегодно занимают до 120 гектаров.
Работа продолжается на опытных участках хозяйств сырьевых зон заводов и по прямым договорам с хозяйствами, сахарными комбинатами.
Направления работы
Главным направлением деятельности Опытной станции является научно-исследовательская работа по проблемам свекловодства, пропаганда и содействие освоению научных разработок в сельскохозяйственном производстве, в том числе:
- создание гибридов сахарной свеклы с использованием селекционно-семеноводческого комплекса и с контролем качества селекционного материала на всех этапах, организация промышленного семеноводства в регионах с благоприятными природными условиями;
- совершенствование технологии возделывания сахарной свеклы с целью получения высокой урожайности и качества корнеплодов при минимальных затратах труда и экономически целесообразных затратах материальных ресурсов;
- мониторинг и анализ хода формирования урожая, контроль элементов технологии возделывания сахарной свеклы и рекомендации по решению возникающих вопросов.
Созданы 5 перспективных гибрида и переданы в Государственное сортоиспытание 2 гибрида сахарной свеклы, устойчивых к болезням листового аппарата и корнеплодов с потенциальной урожайностью 730-780 ц/га и сахаристостью 18%.
Основным путем решения проблемы повышения результативности селекции сахарной свеклы является ускоренное создание гибридов с помощью селекционно-семеноводческого комплекса, введенного в эксплуатацию на Опытной станции в марте 2010 года. Селекционно-семеноводческий комплекс позволяет в течение одного года получать 1-2 генерации перспективных селекционных материалов сахарной свеклы вместо двух лет, необходимых для получения одной генерации в полевых условиях, что в целом в 2-2,5 раза ускорит селекционный процесс.
Лаборатория фитопатологии и иммунитета
Внедрение устойчивых гибридов является наиболее эффективной защитой растений от болезнетворных патогенов. Предпосылкой успешной селекции устойчивого исходного материала является познание болезнетворного фактора и механизмов наследования устойчивости Beta vulgaris к избранным патогенам.
В лаборатории проводится скрининг генетического материала сахарной свеклы по устойчивости к следующим болезням:
– церкоспорозу, фомозу, рамуляриозу, альтернариозу, фузариозу, ризактонии.
Основная задача лаборатории: исследования в области биологии, систематики, экологии фитопатогенных грибов с целью построения на этой основе научно обоснованных систем защиты сахарной свеклы от болезней.
Основные направления исследования лаборатории:
- Изучение особенностей биологии возбудителей наиболее вредоносных болезней сахарной свеклы;Изучение биоразнообразия микромицетов сахарной свеклы.
- Изучение особенностей формирования эпифитотий наиболее вредоносных болезней и выявление факторов способствующих или ингибирующих этот процесс; Изучение устойчивости сортов и гибридов сахарной свеклы к основным возбудителям болезней.
Лаборатория технологических качеств
В настоящее время в селекционно-семеноводческом комплексе осуществляются исследования в аккредитованной лаборатории технологических качеств, оснащенной автоматической линией «Венема», где ежегодно проводится анализ более 5000 образцов для сортоиспытательных участков и сельскохозяйственных предприятий.

Для реализации потенциала продуктивности отечественных сортов и гибридов сахарной свеклы и повышения их конкурентоспособности используется оборудование для дражирования семян, что позволяет подготовить семена с посевными качествами, не уступающими зарубежным аналогам. Также может осуществляться дражирование семян древесных и овощных культур.
Одной из проблем обеспечения потребности республики в семенах сахарной свеклы является несоответствие климатических условий Беларуси требованиям для получения семян гибридов. Фабричное семеноводство наиболее благоприятно в условиях южнее 45 о с. ш. В настоящее время станцией организовано семеноводство в Италии и Сербии.
Проблемы, стоящие перед свекловодческой отраслью, заключаются, в том числе, в решении технологических и организационных вопросов, направленных на интенсификацию производства, улучшение качества продукции. Это — разработка и применение новых форм удобрений, освоение прогрессивных систем защиты растений, комплексное использование элементов технологии возделывания сахарной свеклы.
Станцией разработана усовершенствованная технология возделывания сахарной свеклы, обеспечивающее получение не менее 7,5 тонны сахара с гектара при минимизации трудовых затрат. Площадь освоения этой технологии ежегодно составляет около 20 тыс. га. Разработаны и производятся на базе станции составы для некорневой подкормки микроудобрениями в форме хелатов Поликом-Свекла 1, Поликом-Свекла 2, ПолиПлант. Данные составы являются более технологичными и позволяют заменить импортные аналоги. Прибавка урожайности при их использовании — 28-32 ц/га, сахаристости 0,2-0,5 %,. Составы в последние годы ежегодно используются на площади 20-23 тыс. га.
Разработанная станцией интегрированная система защиты сахарной свеклы от сорняков, вредителей и болезней позволила полностью отказаться от ручных работ на посевах свеклы, минимизировать пестицидную нагрузку на агроэкосистемы, а также в годы эпифитотийного развития и распространения болезней предотвращать потери до 10 % урожая. Система защиты сахарной свеклы используется на всей площади свеклосеяния в Республике Беларусь.
Ежегодно сотрудниками Опытной станции проводится учеба руководителей и специалистов свеклосеющих хозяйств на республиканском, областных и районных уровнях, осуществляется мониторинг развития посевов, готовятся оперативные рекомендации по уходу за посевами, которые размещаются на сайте Министерства сельского хозяйства и продовольствия Республики Беларусь, а также республиканских органах печати.